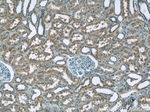
ZIP8 Antibody in Immunohistochemistry (Paraffin) (IHC (P))

Search
Proteintech
ZIP8 Polyclonal Antibody
{{$productOrderCtrl.translations['antibody.pdp.commerceCard.promotion.promotions']}}
{{$productOrderCtrl.translations['antibody.pdp.commerceCard.promotion.viewpromo']}}
{{$productOrderCtrl.translations['antibody.pdp.commerceCard.promotion.promocode']}}: {{promo.promoCode}} {{promo.promoTitle}} {{promo.promoDescription}}. {{$productOrderCtrl.translations['antibody.pdp.commerceCard.promotion.learnmore']}}
产品信息
20459-1-AP
种属反应
已发表种属
宿主/亚型
分类
类型
抗原
偶联物
形式
浓度
规格
纯化类型
保存液
内含物
保存条件
运输条件
产品详细信息
Immunogen sequence: LGGVAEGPG LAFSEDVLSV FGANLSLSAA QLQHLLEQMG AASRVGVPEP GQLHFNQCLT AEEIFSLHGF SNATQITSSK FSVICPAVLQ QLNFHPCEDR PKHKTRPSHS EVWGYGFLSV TIINLAS (18-143 aa encoded by BC012125)
靶标信息
The zinc transporter ZIP8, also known as SLC39A9, is a member of a family of divalent ion transporters. Zinc is an essential ion for cells and plays significant roles in the growth, development, and differentiation. The zinc transporter family is divided into four subfamilies (I, II, LIV-1 and gufA). ZIP8 is glycosylated and located at the plasma membrane and mitochondria. It has been identified as the transporter responsible for transport of the toxic Cadmium cation. ZIP8 has also been suggested to play a role in the regulation of interferon-gamma expression in activated human T cells.
仅用于科研。不用于诊断过程。未经明确授权不得转售。
生物信息学
蛋白别名: BCG induced integral membrane protein BIGM103; BCG-induced integral membrane protein in monocyte clone 103 protein; LIV-1 subfamily of ZIP zinc transporter 6; LZT-Hs6; Metal cation symporter ZIP8; solute carrier family 39 (metal ion transporter), member 8; Solute carrier family 39 member 8; unnamed protein product; Zinc transporter 8; zinc transporter ZIP8; ZIP-8; Zrt- and Irt-like protein 8; ZRT/IRT-like protein 8
基因别名: 4933419D20Rik; AA986696; BIGM103; CDG2N; LZT-Hs6; PP3105; SLC39A8; ZIP-8; ZIP8
UniProt ID: (Human) Q9C0K1, (Mouse) Q91W10
Entrez Gene ID: (Human) 64116, (Mouse) 67547